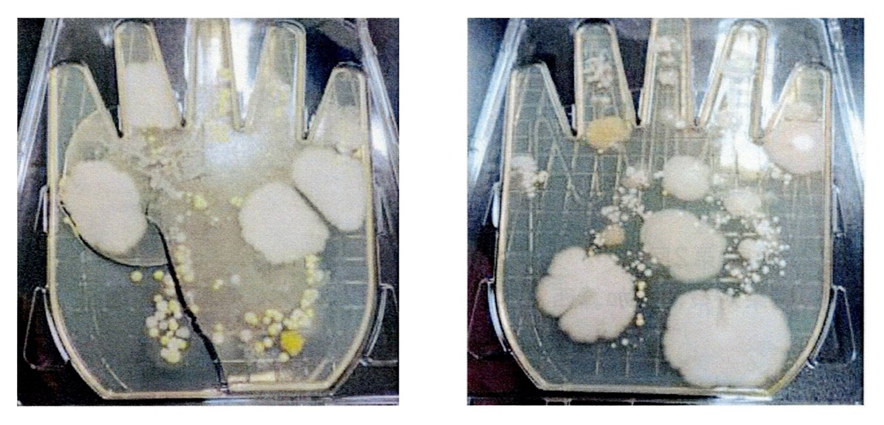

手指消毒の重要性

先月に引き続き、今月もコロナが流行っています。それに加えてインフルエンザもちらほら出始めました。予防にはマスク着用、手指消毒、換気等基本的な事が有効となります。
今回は8月に参加しました西宮の感染対策施設の勉強会でお話のあった手指消毒の重要性についてお話しします。
消毒とは
対象物に付着している病原性のある微生物を害のない程度まで減らすことです。
手指はこんなにも汚染しています
手指衛生の種類と特徴
汚れには目に見える汚れと見えない汚れがあります。
手指衛生の種類と特徴

どちらも15秒以上こすり合わせ、通過菌を除去することで効果があります。
流水石けん手洗いの手順

流水石けん手洗い時の注意点
- 指輪や腕時計は外し、爪は短く整えておく
- 湿ったタオルを介して手が再汚染されたり微生物を伝播させてしまうため、タオルは使用せずまた共用しない
- 使い捨てのペーパータオルを使い、手は完全に乾燥させる
- 手で操作しないといけない蛇口栓の場合、手を拭いたペーパータオルをかぶせて水を止める
- ペーパータオルは濡れないように設置する(ビニールの外装ごと入れない)
- ゴミ箱のフタは洗った手の再汚染防止のため、フットペダル式など手で開けない仕様のものを設置する
- 可能な限り手洗い場は専用にして、使用毎に 周囲の水はねを拭いて乾燥させる
- 液体石鹸は、汚染するため継ぎ足しない
擦式アルコール手指消毒の手順

擦式アルコール手指消毒剤の注意点
- 原則、アルコールを主成分とした製剤を使用する
- 目に見える汚れが付いていない状態で使用する
- 手が乾いた状態で使用する
- 1プッシュは、ポンプを下まで完全に押しきる
- 均等にすり込むことで消毒効果が得られる
一般細菌やウイルスは、20秒程度の接触で死滅するため、20秒位乾かない量の消毒薬を手に取る(手の大きさに合わせる)
手洗い残しを起こしやすい部位

指先や指の間などは特に意識して行うことが重要です
では次に消毒薬の成分と性状についてお話しします
手指消毒薬の成分と性状
- アルコールが主成分であることが基本
- アルコール濃度が70〜90%程度の製剤が適している
- アルコール過敏症や手荒れがひどいときは アルコール成分ではない製剤の使用も考慮する
手指消毒薬の性状 ~液状~
- 粘度が低い
- すばやく手指全体を消毒薬に接触できる
- 1回の用量が多い
- こぼれやすく、無駄になりやすい
手指消毒薬の性状 ~ジェル状~
- 粘度が高く、伸ばしやすい
- こぼれにくい
- 1回の用量が少ない
- ムダなくゆっくり擦り込むことができる
手指消毒薬の性状 ~泡状~
- 消毒された場所を目視で確認できる
- 塗布範囲がわかりやすい
- 飛び散らず、液だれしない
- 小児や高齢者でも使いやすい
手指消毒したり石けんで手洗いをすると手荒れする方もいらっしゃると思います。
最後に手荒れ防止のポイントをお話しします。
手荒れ防止のポイント
手荒れ部分に細菌が定着し交差感染の危険性が増えるため、下記の対策を行う
- 刺激の少ない石けんまた擦式手指消毒剤を使用する
- 十分な水で石けんの化学成分を完全に洗い流す
- ペーパータオルで強くこすらないように、優しく 軽く 叩くようにして水分を拭き取り、完全に手指を乾燥させる
- 皮脂の除去につながる温水の使用は避ける
- 日頃から保湿効果のあるクリームなどで ハンドケアを行う・手荒れや傷がある時はメンテ袋を使用する・対策しても治癒しない場合は皮膚科受診を進める
荒れ防止のポイント
手荒れ部分に細菌が定着し交差感染の危険性が増えるため、下記の対策を行う
- 刺激の少ない石けんまた擦式手指消毒剤を使用する
- 十分な水で石けんの化学成分を完全に洗い流す
- ペーパータオルで強くこすらないように、優しく 軽く 叩くようにして水分を拭き取り、完全に手指を乾燥させる
- 皮脂の除去につながる温水の使用は避ける
- 日頃から保湿効果のあるクリームなどで ハンドケアを行う・手荒れや傷がある時はメンテ袋を使用する・対策しても治癒しない場合は皮膚科受診を進める
皮膚科医がおすすめするハンドケア
配合成分によって、様々な効果が期待できるため、手の悩みに合う成分が配合されているかチェックしましょう

手の乾燥を防ぎたい方へおすすめのハンドクリーム
- 保湿効果のあるヘパリン類似物質やセラミド、シアバターが配合しているもの
- 皮膚の表面に膜を張る効能のあるワセリンも乾燥防止に効果的
- 角質軟化作用をもつ尿素やグリセリンは、カサカサ感の改善が期待できる
手荒れが気になる方へのおすすめのハンドクリーム
- 乾燥を防ぐことが大事なので保湿成分含有が効果的かつ抗炎症作用のあるグリチルリチン酸が配合されたものを選ぶといい
- ビタミンE(トコフェロール)が配合されたクリームも手荒れの防止に効果がある
これから冬の時期になるにつれ、ますますインフルエンザの流行も拡大されることが予測されます。是非、きちんと手指消毒を行い、御自身のお体を守って下さい。
- 西宮さくら夙川 みやけ内科クリニック -
JR神戸線 さくら夙川駅前(改札を出てすぐ目の前)
お問合せ
受付時間内にお電話でお問合せをお願いします
アクセス
兵庫県西宮市神楽町11-27 ブルーノ夙川2F


